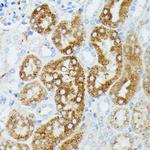
MEKK1 Antibody in Immunohistochemistry (Paraffin) (IHC (P))
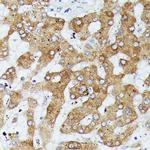
MEKK1 Antibody in Immunohistochemistry (Paraffin) (IHC (P))
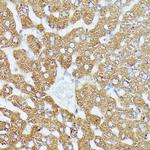
MEKK1 Antibody in Immunohistochemistry (Paraffin) (IHC (P))

Search
Invitrogen
MEKK1 Polyclonal Antibody
{{$productOrderCtrl.translations['antibody.pdp.commerceCard.promotion.promotions']}}
{{$productOrderCtrl.translations['antibody.pdp.commerceCard.promotion.viewpromo']}}
{{$productOrderCtrl.translations['antibody.pdp.commerceCard.promotion.promocode']}}: {{promo.promoCode}} {{promo.promoTitle}} {{promo.promoDescription}}. {{$productOrderCtrl.translations['antibody.pdp.commerceCard.promotion.learnmore']}}
产品信息
PA5-109933
宿主/亚型
分类
类型
抗原
偶联物
形式
浓度
规格
保存条件
运输条件
RRID
产品详细信息
Sequence of this protein is as follows: TGAGEFQGQL LGTIAFMAPE VLRGQQYGRS CDVWSVGCAI IEMACAKPPW NAEKHSNHLA LIFKIASATT APSIPSHLSP GLRDVALRCL ELQPQDRPPS RELLKHPVFR TTW
靶标信息
Mitogen-activated protein kinase (MAPK) signaling cascades include MAPK or extracellular signal-regulated kinase (ERK), MAPK kinase (MKK or MEK), and MAPK kinase kinase (MAPKKK or MEKK). MAPKK kinase/MEKK phosphorylates and activates its downstream protein kinase, MAPK kinase/MEK, which in turn activates MAPK. The kinases of these signaling cascades are highly conserved, and homologs exist in yeast, Drosophila, and mammalian cells. MEKK1 can phosphorylate and activate MAPKK 1 and MAPKK 2 (MEK1/MEK2) which leads to phosphorylation of MAP kinases. It is also a highly efficient activator of the JNK cascade. The protein contains a putative 1 RING-type zinc finger and 1 SWIM-type zinc finger.
⚠WARNING: This product can expose you to chemicals including mercury, which is known to the State of California to cause birth defects or other reproductive harm. For more information go to www.P65Warnings.ca.gov.
仅用于科研。不用于诊断过程。未经明确授权不得转售。